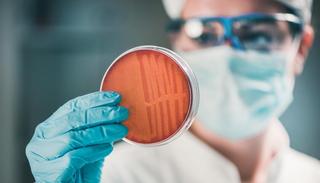

文 | 李根
11月25日晚,成都迈克生物股份有限公司发布公告称,已于当日与成都天府国际生物城管理委员会签署了投资合作协议,拟取得成都天府国际生物城86亩用地,并在国际生物城设立全资独立法人企业,投资建设迈克生物IVD天府产业园项目,项目总投资不低于13.8亿元。

作为成都本土的一家体外诊断上市公司,迈克生物始创于1994年,主营业务涉及自产试剂、自产仪器、代理试剂、代理仪器及其他业务,自主产品涵盖生化诊断、免疫诊断、分子诊断、血球诊断、微生物诊断、POCT、生物原料等技术平台。
自2015年上市以来,迈克生物业绩一直保持较快增速,据此前不久其公布第三季度财报显示,公司2019年前三季度收入同比增长20.11%至23.48亿元,净利润同比增长16.50%至4.14亿元;2019年三季度收入同比增长17.26%至8.31亿元,净利润同比增长16.94%至1.45亿元。
对于此次与天府国际生物城的投资合作,迈克生物表示,作为国内IVD全产业链和全产品线布局的行业龙头,迈克生物IVD天府产业园将进一步优化公司产能布局,提升公司在行业内的领先地位和核心竞争力,对公司具有积极的战略意义。
另一方面,成都天府国际生物城作为构建成都市生物产业发展的主阵地,将集成高新区产业、创新、人才、金融等政策优势,其产业定位和发展规划有利于迈克生物的长期发展,也有助于推动公司在体外诊断技术创新和产品制造能力方面的国际化进程。
据悉,此次投资建设的迈克生物IVD天府产业园项目,包含体外诊断血球产品、清洁液产品两个子项目。
其中体外诊断血球产品项目从事体外诊断产品中血球产品的研发及生产业务,建设F560、F580、F800等高端全自动血细胞分析仪配套血球试剂生产线,工艺用水生产线,10吨和20吨自动化配液生产线等;清洁液产品项目从事各产品平台清洁液的研发及生产业务,建设清洁液产品生产线。
同时,两项子项目还将建设智能留样车间,原料、半成品冷藏冷冻库等,力争建成为国内最具专业性、规模化和建筑风格的一流体外诊断产品产业园区。
在规模方面,项目总用地约86亩,总建筑面积不低于11.83万平方米(项目用地容积率不小于2.0,建筑密度不低于40%)。总投资不低于13.8亿元,其中固定资产投资不低于11亿元,研发投资约2亿元。
自项目投产之日起第1-5年,预计员工规模每年累计分别不低于80人、120人、150人、180人、220人,年科技研发投入费用占年营业收入比重将不低于5%,年营业收入分别不低于2.05亿元、3.06亿元、3.68亿元、4.41亿元、5.29亿元。
